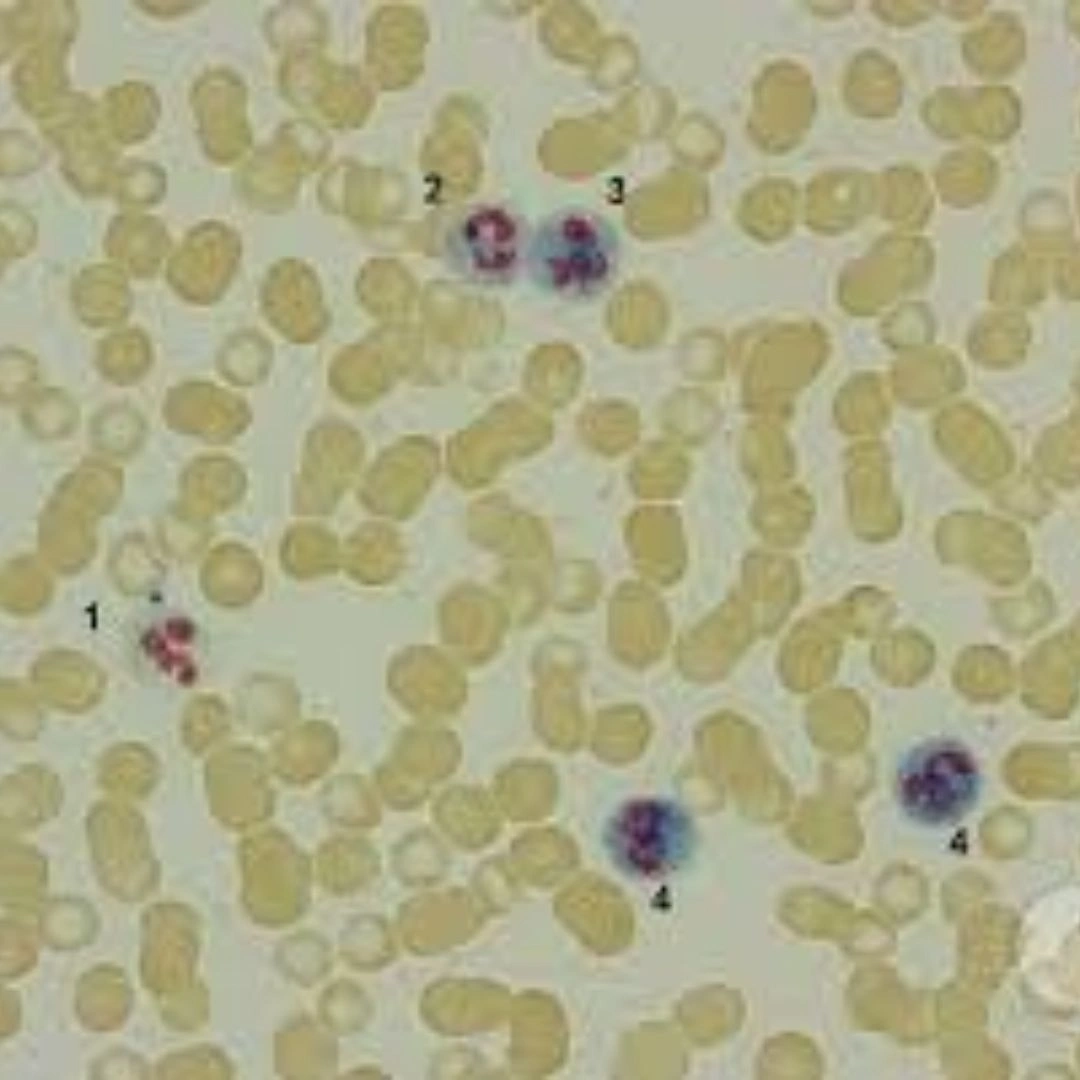
Lap (Leucocyte Alkaline Phosphatase/Neutro- Phil Alk

LAP (Leucocyte Alkaline Phosphatase / Neutrophil Alkaline Phosphatase)
What it is
The Leucocyte Alkaline Phosphatase (LAP) test measures the activity of alkaline phosphatase enzyme in white blood cells, specifically neutrophils. It is performed by staining and scoring neutrophils for enzyme activity. The LAP score helps differentiate between certain blood disorders, particularly chronic myeloid leukemia (CML) and reactive conditions like infections or stress responses.
Uses
This test is primarily used in the diagnosis and differentiation of blood disorders. A low LAP score is strongly associated with CML, while high scores are typically seen in conditions such as infections, polycythemia vera, myelofibrosis, or leukemoid reactions. It may also be used as part of a broader evaluation of unexplained abnormal white blood cell counts.
Symptoms That May Lead to the Test
Doctors may recommend an LAP test if you present with persistently high or abnormal white blood cell counts, fatigue, weight loss, night sweats, frequent infections, splenomegaly (enlarged spleen), unexplained bruising, or other symptoms suggestive of leukemia or bone marrow disorders.
Abnormal Results
Low LAP Score: Strongly suggests chronic myeloid leukemia (CML) or paroxysmal nocturnal hemoglobinuria (PNH). Further genetic testing such as the BCR-ABL test is usually required for confirmation.
High LAP Score: May indicate infections, inflammatory conditions, leukemoid reactions, myeloproliferative disorders (like polycythemia vera or myelofibrosis), or pregnancy. It generally reflects increased neutrophil activity due to stress or disease.
Risks
The test requires a standard blood draw, with minimal risks such as slight pain, bruising, or dizziness at the puncture site. Serious complications are extremely rare. The analysis itself is pe

Reviews
There are no reviews yet.